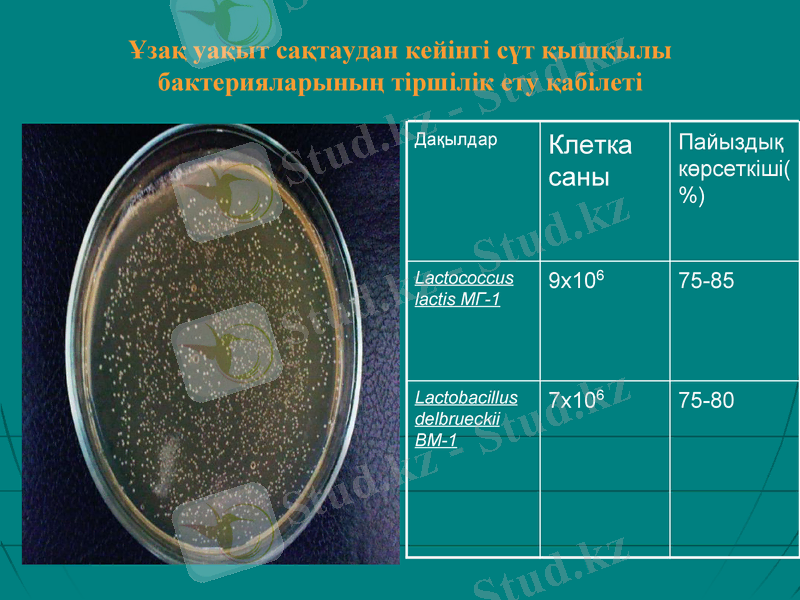
Slide 4
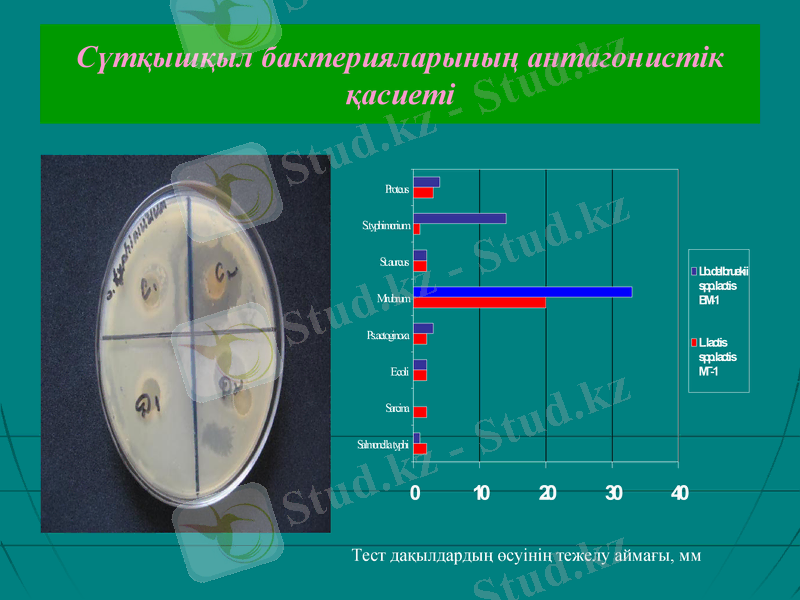
Slide 7

Лиофильді сақталған Lactococcus lactis және Lactobacillus delbrueckii штаммдарының биологиялық қасиеттерінің тұрақтылығын зерттеу



Ұзақ уақыт сақталған сүтқышқыл бактериялар қасиеттерінің тұрақтылығын зерттеу
Ғылыми жетекші: б. ғ. к., доцент Абдиева Г. Ж.
Орындаған: Жусипова Д. А.

■ Бітіру жұмысының өзектілігі: Қазіргі таңда сүтқышқылы бактерияларын қолдану арқылы дайындалған өнімдер мен препараттар адамның функционалды тағамы ретінде қолданылады. Лактобактериялардың тірі клеткалары немесе олардың метаболиттерін пробиотикалық тағамдар мен препаратар арқылы қабылдау адам организмін сауықтырады. Осы мақсатта арнайы таңдалып алынған сүтқышқылы бактериялардың биолгиялық құнды қасиеттерінің маңызы орасан зор.
■ Бітіру жұмысының мақсаты:
Сүт қышқылды өнімдерді өндіруде пайдаланылатын ұйытқы алу мақсатында әртүрлі субстраттардан бөлініп алынған сүтқышқылды бактериялардың биологиялық маңызды қасиеттерінің тұрақтылығын зерттеу.
■ Бітіру жұмысының міндеті: 1) лиофильді кептірілген биомассадағы сүтқышқылды бактериялардың ұзақ уақыт сақтаудан кейінгі тіршілікке қабілеттілігін анықтау; 2) сүтқышқылды бактериялардың морфология-культуральдық, физиология-биохимиялық қасиеттерінің тұрақтылығын зерттеу; 3) сүтқышқылды бактериялардың антагонистік белсенділігін анықтау; 4) сүтқышқылды бактериялардың антибиотикке төзімділігін зерттеу;
5) Белсенді сүтқышқыл бактериялар негізінде зертханалық жағдайда сүтқышқылдық өнім алу.

Зерттеу объектісі:
Lactococcus lactis МГ - 1
Lactobacillus delbrueckii ВМ-1
Ұзақ уақыт сақтаудан кейінгі сүт қышқылы бактерияларының тіршілік ету қабілеті
Дақылдар
Клетка саны
Пайыздық көрсеткіші(%)
Lactococcus lactis МГ-1
9x106
75-85
Lactobacillus delbrueckii ВМ-1
7x106
75-80

Сүтқышқыл бактериялардың сүтте өсуі
Lactococcus lactis МГ - 1
Ұйытқы біртекті түзілген, 1-2 пробиркада бетінде аздап сарысу түзілген.
Ұйытқы түзген уақыты -
Lactobacillus delbrueckii
ВМ-1
ұйытқы түзілген, алайда біртекті емес. Сарысу түбінде, арасында және бетінде түзілген.
Ұйытқы түзген уақыты -

Сүт қышқылы бактерияларының қышқыл түзу белсенділігі
Штамдар
Сүтқышқыл бактерияларының антагонистік қасиеті
Тест дақылдардың өсуінің тежелу аймағы, мм

Сүт қышқылды бактериялардың антибиотикке сезімталдығын
Дақылдар
Сүт қышқыл бактериялар өсуінің тежелу аймағының мөлшері (мм)
Эритромицин(10)
Ампециллин (10)
Карбециллин(25)
Цефтриаксон (30)
Цефамандол(30)
Ципрофлоксацин(15)
Ванкомицин (30)
Тетрациклин(10)
Рифампицин(2)
Неомицин(30)
Линкомицин (10)
L. lactis
21+-мм
21 мм
12 мм
9 мм
-
-
16 мм
8 мм
8 мм
17 мм
10 мм
Lb. delbrueckii
16мм
11 мм
25 мм
17 мм
15 мм
3 мм
16 мм
11 мм
9 мм
13 мм
13 мм

Сүтқышқылды сусындар

Сүтқышқылды сусындардың физика-химиялық қасиеттері
№
Дақылдар
Органолиптикалық қасиеттері
Қышқыл түзу белсенділігі
рН
дәмі
иісі
түсі
1
5%Lb+5%Lc
Айранға ұқсайды
Тәтті
ақ
86°T+-
4. 70
2
Lc 10%
айран
Айранға ұқсас
ақ
50°T+-
5. 25
3
Lb 10%
Тәтті
Дәмді
ақ
62°T+-
5. 43
4
Lc 5%
Айран
Айранға ұқсас
ақ
58°T+-
5. 26
5
Lb 5%
Тәтті
әдемі
ақ
81°T
5. 20
6
Lb 2. 5% + Lc 2. 5%
ароматты
ақ
83°T
4. 90

Қорытынды
Микробиология кафедрасының коллекциясында ұзақ уақыт лиофильді кептіру әдісімен сақталған Lactococcus lactis МГ-1, Lactobacillus delbrueckii ВМ-1 (сәйкесінше) штамдарының биотехнологияда маңызды қасиеттері зерттелініп, тіршілікке қабілетті клеткаларының саны анықталынынды, пайыздық шамамен 75-80%-ға тең екендігі көрсетілді.
Қышқыл түзу белсенділігі Lactobacillus delbrueckii ВМ-1 штаммында жоғары (170°T), ал Lactococcus lactis МГ-1, штаммында орташа (125°Т) екендігі анықталынды.
Cүтқышқыл бактериялары Mycobacterium rubrum, S. typhimorium, Proteus дақылдарына жоғары антагонистік белсенділік көрсетсе, Salmonella typhi, Sarcina дақылдарына әлсіз антагонистік белсенділік көрсетті.
Cүтқышқыл бактериялары тетрациклин, рифампицин, цефтриаксон антибиотиктеріне төмен көрсетті. Ал эритромицин, ванкомицин, ампециллин антибиотиктеріне жоғары төзімділік танытты.
Осы қасиеттерінің негізінде сүтқышқылды сусын алынды.
- Іс жүргізу
- Автоматтандыру, Техника
- Алғашқы әскери дайындық
- Астрономия
- Ауыл шаруашылығы
- Банк ісі
- Бизнесті бағалау
- Биология
- Бухгалтерлік іс
- Валеология
- Ветеринария
- География
- Геология, Геофизика, Геодезия
- Дін
- Ет, сүт, шарап өнімдері
- Жалпы тарих
- Жер кадастрі, Жылжымайтын мүлік
- Журналистика
- Информатика
- Кеден ісі
- Маркетинг
- Математика, Геометрия
- Медицина
- Мемлекеттік басқару
- Менеджмент
- Мұнай, Газ
- Мұрағат ісі
- Мәдениеттану
- ОБЖ (Основы безопасности жизнедеятельности)
- Педагогика
- Полиграфия
- Психология
- Салық
- Саясаттану
- Сақтандыру
- Сертификаттау, стандарттау
- Социология, Демография
- Спорт
- Статистика
- Тілтану, Филология
- Тарихи тұлғалар
- Тау-кен ісі
- Транспорт
- Туризм
- Физика
- Философия
- Халықаралық қатынастар
- Химия
- Экология, Қоршаған ортаны қорғау
- Экономика
- Экономикалық география
- Электротехника
- Қазақстан тарихы
- Қаржы
- Құрылыс
- Құқық, Криминалистика
- Әдебиет
- Өнер, музыка
- Өнеркәсіп, Өндіріс
Қазақ тілінде жазылған рефераттар, курстық жұмыстар, дипломдық жұмыстар бойынша біздің қор #1 болып табылады.



Ақпарат
Қосымша
Email: info@stud.kz